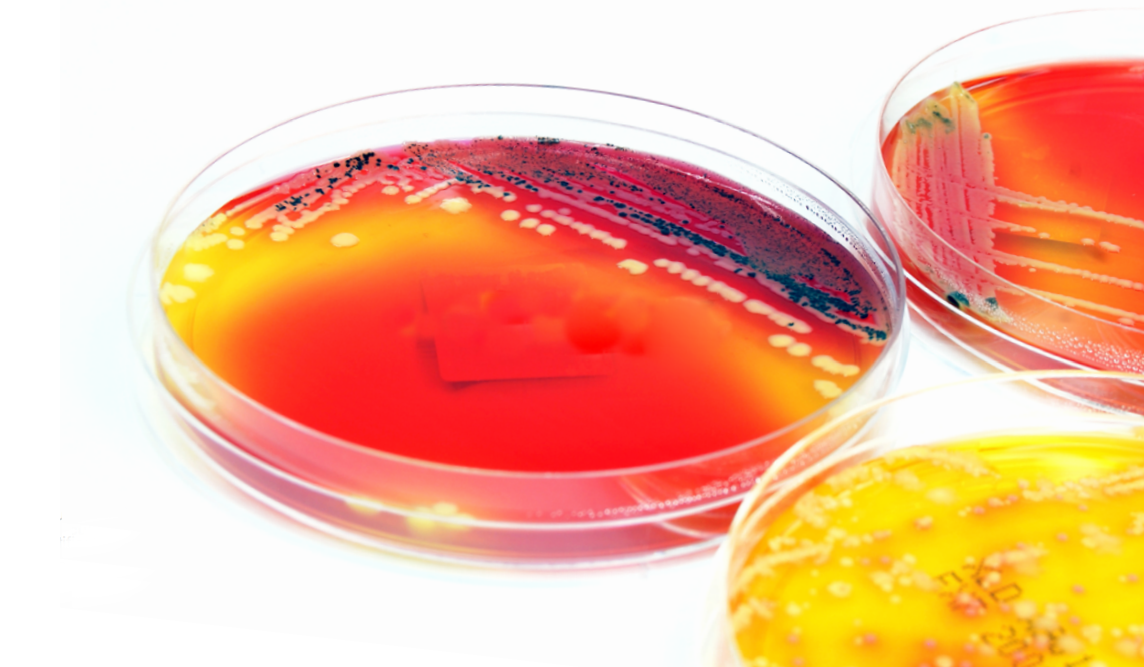

SISTEMAS DE ENSAYO LAL
Accugenix
La secuenciación comparativa de ADN del gen 16S rRNA en bacterias y de la región ITS2 rRNA en hongos es reconocida en la industria como el método más preciso y reproducible para la identificación de microorganismos desconocidos. Accugenix utiliza la tecnología de secuenciación Sanger mediante sus sistemas BacSeq (identificación bacteriana) y FunITS(identificación fúngica) para obtener resultados fiables en tan solo seis horas.
La técnica de secuenciación microbiana Sanger es ideal para la identificación demicroorganismos, ya que las condiciones de salud o crecimiento del aislado no afectan el resultado. Las muestras para la secuenciación microbiana pueden ser cultivos viables o no viables, o simplemente ADN genómico del microorganismo. La secuencia de ADN resultante de cada aislado enviado para su identificación se compara con la biblioteca microbiana validada de Accugenix: la base de datos de secuenciación más completa, relevante y actualizada del sector para el monitoreo ambiental.
La técnica de secuenciación microbiana Sanger es ideal para la identificación demicroorganismos, ya que las condiciones de salud o crecimiento del aislado no afectan el resultado. Las muestras para la secuenciación microbiana pueden ser cultivos viables o no viables, o simplemente ADN genómico del microorganismo. La secuencia de ADN resultante de cada aislado enviado para su identificación se compara con la biblioteca microbiana validada de Accugenix: la base de datos de secuenciación más completa, relevante y actualizada del sector para el monitoreo ambiental.
¿Por qué externalizar los servicios de identificación por secuenciación microbiana con Accugenix?
Más de un millón de identificaciones microbianas realizadas en los últimos 10 años.
El proceso de identificación por secuenciación Sanger de Accugenix cumple con las normas cGMP.
La tasa de detección más alta del sector, del 90%, con una repetibilidad seis veces superior a la de otros sistemas de identificación.
Bibliotecas validadas que se mantienen y actualizan continuamente para reflejar los últimos cambios taxonómicos y la publicación de nuevos organismos, como el grupo Bacillus cereus.
Nuestras bibliotecas de secuenciación microbiana validadas contienen actualmente más de 16.488 organismos para la identificación de bacterias y hongos.
Especies microbianas relevantes en nuestras bibliotecas de secuenciación que reflejan los organismos presentes en los entornos de fabricación de productos farmacéuticos.
Más de un millón de identificaciones microbianas realizadas en los últimos 10 años.
El proceso de identificación por secuenciación Sanger de Accugenix cumple con las normas cGMP.
La tasa de detección más alta del sector, del 90%, con una repetibilidad seis veces superior a la de otros sistemas de identificación.
Bibliotecas validadas que se mantienen y actualizan continuamente para reflejar los últimos cambios taxonómicos y la publicación de nuevos organismos, como el grupo Bacillus cereus.
Nuestras bibliotecas de secuenciación microbiana validadas contienen actualmente más de 16.488 organismos para la identificación de bacterias y hongos.
Especies microbianas relevantes en nuestras bibliotecas de secuenciación que reflejan los organismos presentes en los entornos de fabricación de productos farmacéuticos.
Envío de muestras para secuenciación microbiana
La secuenciación microbiana de Accugenix requiere cultivos frescos, por lo que las muestras deben estar vivas y sanas. Los cultivos vivos deben enviarse durante la noche a temperatura ambiente. El tiempo total transcurrido desde la inoculación de la muestra hasta su llegada no debe superar las 48 horas. Los cultivos vivos con más de 48 horas de antigüedad podrían requerir subcultivo.
La secuenciación microbiana de Accugenix requiere cultivos frescos, por lo que las muestras deben estar vivas y sanas. Los cultivos vivos deben enviarse durante la noche a temperatura ambiente. El tiempo total transcurrido desde la inoculación de la muestra hasta su llegada no debe superar las 48 horas. Los cultivos vivos con más de 48 horas de antigüedad podrían requerir subcultivo.

